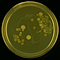

Experimentiertag 2012
Saurier und Kaviar haben auf den ersten Blick nichts miteinander zu tun. Beim Experimentiertag am 26. Juli 2012 erhielten Schüler der Klassen 2-9 die Gelegenheit für einen zweiten Blick. In einer Vorlesung für junge Leute erläuterte Professor Wünschiers, dass Erzählungen und Darstellungen drachenartiger Fabelwesen wie dem Greif wahrscheinlich aus der Überlieferung von Begegnungen des Menschen mit Dinosaurierfossilien entsprangen. Was mussten das für Ungeheuer sein, die meterlange, steinerne Knochen haben. Tatsächlich wogen Sauropoden bis zu 75 t. Was müssen die für einen Hunger gehabt haben - was für gigantische Leibeswinde sind ihnen entfahren? Damit war ein brandaktuelles Thema angesprochen: die Biogaserzeugung. Unzählige, mikroskopisch kleine Bakterien verwandeln Bioabfälle, Gülle und Pflanzenmaterial in brennbares Methan. Ihre Werkzeuge nennt der Biotechnologe Enzyme. Und diese sind ihm wichtig und teuer - daher möchte er sie festketten, also immobilisieren. Eine Möglichkeit haben die Schüler gemeinsam mit unseren Laboringenieuren Frau Feik und Herrn Kretschmer selber ausprobiert: statt Enzyme haben sie Fruchtsirup mit Hilfe von Alginat immobilisiert. Das sah dann aus wie Kaviar - und hat den meisten leider nicht so doll geschmeckt wie Bubble Tea.
Um zu zeigen, dass Bakterien nicht nur bei der Biogaserzeugung und der Verdauung helfen, sondern auch unsere Haut besiedeln, haben die Schüler ihren mikrobiologischen Fingerabdruck hinterlassen. Das Ergebnis befindet sich unten. Mit einem Blick in den Mikrokosmos durch das Mikroskop und der Bewunderung einer fluoreszierenden transgenen Bakterienkultur schloss der Tag in der Biotechnologie ab.